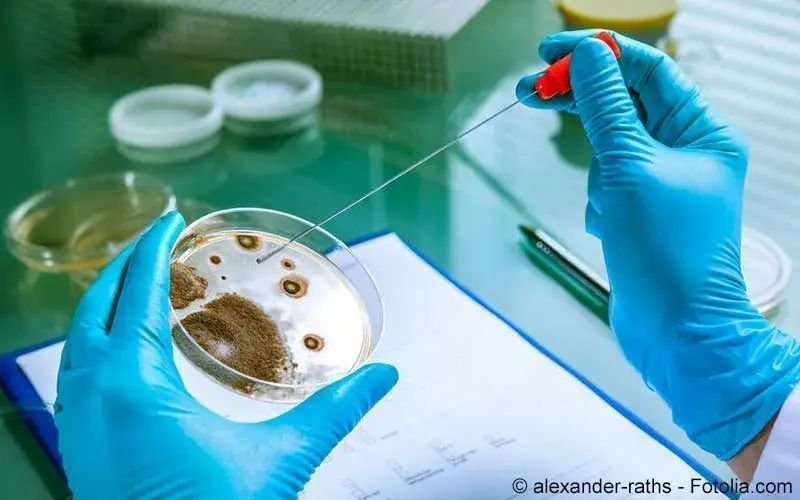
Brucellose

Brucellose
Brucellose ist eine sehr seltene Infektionskrankheit, die von Tieren auf den Menschen übertragen wird. Ohne rechtzeitige Therapie kann sie schwere Entzündungen hervorrufen....
by Kaz Liste B
Brucellose ist eine sehr seltene Infektionskrankheit, die von Tieren auf den Menschen übertragen wird. Ohne rechtzeitige Therapie kann sie schwere Entzündungen hervorrufen....
by Kaz Liste BBrucellose ist eine sehr seltene Infektionskrankheit, die von Tieren auf den Menschen übertragen wird. Ohne rechtzeitige Therapie kann sie schwere Entzündungen hervorrufen. Mehr über Symptome, Ursachen und Behandlung.
Morbus Bang, Maltafieber, Mittelmeerfieber, Bangkrankheit, undulierendes Fieber
Als Brucellose bezeichnen Mediziner eine Infektion mit Bakterien der Gattung Brucella. Diese Infektionen treten vor allem bei Rindern, Schweinen, Hunden, Ziegen, Kamelen und Schafen auf. In den Tierarten siedeln diverse Brucellaarten, die unterschiedliche Brucelloseformen wie Morbus Bang oder das Mittelmeerfieber auslösen.
Auf den Meneschen übertragen werden die Brucella-Bakterien vor allem durch Fleisch und Milch von infizierten Tieren. In den meisten Fällen (90 Prozent) wehrt das menschliche Immunsystem die Brucellen erfolgreich ab. Bei den übrigen 10 Prozent verläuft die Infektion entweder akut oder chronisch. Die akute Verlaufsform ist meist harmlos. Die chronische Brucellose hingegen kann schwer verlaufen. Sie führt mitunter zu komplikationsträchtigen Entzündungen von Organen oder Skelettteilen. Die Behandlung von Brucellose erfolgt durch eine antibiotische Therapie.
Deutschland gilt als frei von Brucellose. Diese Angabe bezieht sich allerdings auf Zuchtbestände der infrage kommenden Tierarten. Für wild lebende Tiere und Importtiere lässt sich Brucellose nicht sicher aussschließen. Das Robert-Koch-Institut registrierte in den vergangenen Jahren in der Spitze 37 Fälle. Am häufigsten stammten infizierte Tiere demnach aus der Türkei. Weltweit wird die Zahl der Brucellose-Infektionen von Menschen mit 500.000 Infektionen pro Jahr angegeben.
In 90 Prozent der Fälle bleibt eine Infektion mit Brucella-Bakterien ganz oder nahezu ohne Symptome. In 10 Prozent der Fälle kommt es zu wahrnehmbaren Krankheitszeichen. Diese Symptome unterscheiden sich je nachdem, ob die Brucellose akut oder chronisch verläuft. Die Symptome können wenige Tage nach der Ansteckung einsetzen. Mitunter beträgt die Inkubationszeit aber auch bis zu zwei Jahre.
Eine akute Brucellose äußert sich vor allem durch Schüttelfrost, Nachtschweiß und Übelkeit. Zudem kommen oft grippeähnliche Symptome wie:
Fieber (vor allem bei Mittelmeerfieber mit wellenartigem Verlauf; undulierendes Fieber)Kopfschmerzengeschwollene LymphknotenGliederschmerzenMüdigkeitLeber- und Milzschwellungenverlangsamter Herzschlag (Bradykardie)Wird eine akute Brucellose nicht erkannt oder nicht behandelt, geht sie in 5 Prozent der Fälle in die chronische Verlaufsform über.
Die chronische Brucellose verursacht mitunter schwer verlaufende Entzündungen von Knochen und Gelenken sowie im Urogenitalbereich. Überdurchschnittlich oft betroffen sind die Bandscheiben im Bereich der Lendenwirbelsäule (Spondylodiszitis). Bei Männern kommt es in 10 von 100 Fällen zu Hodenentzündung (Orchitis) oder Nebenhodenentzündung (Epididymitis). Nicht selten verursacht chronische Brucellose zudem psychische Symptome wie Stimmungsschwankungen oder sogar Depressionen. Auch Schlafstörungen können auf eine Brucella-Infektion zurückgehen.
Weitere seltene Organ-Komplikationen von Brucellose sind:
Augenentzündung (Uveitis)Bauchfellentzündung (Peritonitis)Bauchspeicheldrüsenentzündung (Pankreatitis)Gallenblasenentzündung (Cholezystitis)Herzinnenhautentzündung (Endokarditis)HerzklappenentzündungHirnhautentzündung (Meningitis)Lungenentzündung (Pneumonie)Vergrößerung von Leber und Milz (Hepatosplenomegalie).Brucellose wird durch eine Infektion mit Brucella-Bakterien verursacht. Dabei handelt es sich um gramnegative Bakterien unterschiedlicher Arten. Die Brucella-Arten kommen spezifisch in Tierarten vor und verursachen leicht unterschiedliche Formen der Brucellose. Am häufigsten auf den Menschen übertragen werden:
Brucella abortus verursacht die Bang-Krankheit. Der Erreger kommt vor allem in Rindern vor.Brucella melitensis gilt als Erreger von Maltafieber (Mittelmeerfieber). Diese Brucellaart findet sich vor allem in Ziegen, Schafen und Kamelen.Zudem gibt es Brucellaarten, die in Schweinen (Brucella suis) oder Hunden (Brucella canis) siedeln. Diese spielen für die Infektion von Menschen aber kaum eine Rolle.
Brucellabakterien werden meistens durch Lebensmittel aus infizierten Tieren übertragen. Das sind vor allem rohes Fleisch oder Rohmilchprodukte. Auch mit dem Kot oder Urin infizierter Tiere gelangen die Bakterien durch kleinste Hautverletzungen in den menschlichen Körper.
Eine Ansteckung von Mensch zu Mensch ist nach Angaben des Robert-Koch-Instituts sehr selten. Demnach besteht das größte Risiko, wenn infizierte Mütter die Bakterien beim Stillen weitergeben. Wegen der Ansteckungsgefahr sollten an Brucellose erkrankte Frauen nicht stillen. Die Muttermilch darf jedoch verwendet werden, wenn sie abgepumpt und anschließend abgekocht wurde.
Die Behandlung von Brucellose erfolgt medikamentös. Laut Richtlinien werden bei einer akuten Brucellose 2 Antibiotika nacheinander angewendet. Am Anfang steht eine 6-wöchige Behandlung mit dem Antibiotikum Doxycyclin. Daran schließt sich eine 2- bis 3-wöchige Therapie mit Streptomycin an. Alternativ zu Streptomycin kann auch Rifampicin gegeben werden.
Kinder und Schwangere erhalten in der Regel für 6 Wochen eine Kombinationstherapie aus den Antibiotika Cotrimoxazol und Rifampicin.
Chronische Brucellose erfordert in der Regel eine noch längere Antibiose. Mitunter dauert die medikamentöse Behandlung bis zu 6 Monate oder länger.
In den allermeisten Fällen lässt sich Brucellose mit einer antibiotischen Therapie erfolgreich behandeln. Allerdings ist die Behandlung mitunter langwierig.
In seltenen Fällen (laut RKI weniger als 2 Prozent) verlaufen Herzinnenhautentzündungen als Komplikation von unbehandelter chronischer Brucellose tödlich.
 P
P
Wenn der Mutterkuchen das Neugeborene nicht ausreichend mit Nährstoffen und Sauerstoff versorgen kann, bezeichnen Mediziner das als Plazentainsuffizienz...
 K
K
Symptome, Ursachen und Behandlung von Knochenentzündungen wie Ostitis und Osteomyelitis im Überblick...